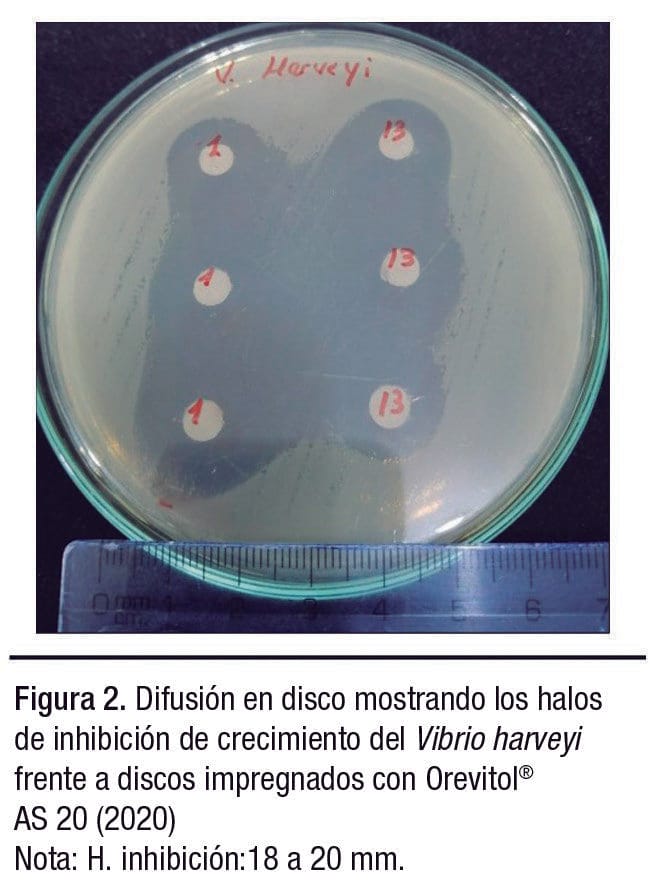
Programa Aqua-CKM

CKM, empresa peruana, contribuye con productos alternativos y naturales que potencian la sostenibilidad y rentabilidad del sector acuícola, a través de su Programa Aqua-CKM y sus productos fitobióticos Orevitol® AS 20 y Liverin-L®, con resultados positivos de productividad en el cultivo del camarón Litopenaeus vannamei.
CKM, empresa peruana con 28 años de trayectoria en la industria de producción, se dedica a la investigación, innovación y desarrollo de productos farmacéuticos y productos alternativos naturales.
Consciente de la actual exigencia del mercado mundial respecto al retiro de antibióticos en la producción animal, CKM está orientada a ofrecer programas con productos alternativos naturales capaces de ser usados de forma continua y eficiente en campo por avicultores, porcicultores y acuicultores.

CKM con su enfoque de investigación continua, contribuye con la sostenibilidad de la cadena de valor de la industria alimentaria, mejorando la nutrición, rendimiento y bienestar del animal.
Además, constata que el consumidor final pueda gozar de carnes más inocuas y seguras para su consumo y que el productor logre una mayor sostenibilidad en su proceso productivo; apuntando de esta manera hacia su visión de ser una empresa líder en proponer productos y tecnología con estándares internacionales de calidad que, a su vez, sean sostenibles con el medio ambiente, convirtiéndola en una empresa pionera en investigación y manejo de productos fitobióticos como una alternativa al uso de antibióticos.
Asimismo, CKM tiene como misión proveer productos y servicios con valor agregado a la industria, que mejoren la productividad de sus clientes, objetivos que cumple estrictamente a través de la certificación e implementación de su “Sistema de Gestión de Calidad”, “Buenas Prácticas de Manufactura” y “Buenas Prácticas de Almacenamiento”.
Además, cuenta con profesionales de primer nivel en sus áreas de producción, logística y calidad, así como en los servicios técnicos de nutrición y sanidad para beneficio del productor y la industria. En particular, ofrece un innovador programa y productos para la industria acuícola.
CKM en la acuicultura
CKM no detiene la investigación ni los esfuerzos por colaborar con la sostenibilidad en la producción de proteína animal.
Por esta razón, la empresa continúa en la evaluación de nuevas moléculas que logren su compromiso y objetivo de aportar productos naturales alternativos y programas innovadores, pero ahora enfocados en las necesidades del sector acuícola latinoamericano; con el fin de ofrecer valor a través de programas con productos alternativos naturales que puedan ser utilizados de forma habitual y segura, permitiendo además maximizar la productividad y rentabilidad de las empresas de la industria.
“Para ello, pone a disposición de los productores acuícolas el uso de fitobióticos, asistencia técnica especializada y asesoría pre y postventa, con especial atención en especies clave para el mantenimiento y desarrollo de esta industria.”
La exportación del camarón L. vannamei es la principal actividad del sector, la cual se rige por estrictos estándares internacionales de inocuidad y exige un organismo con ciertas características (peso, calidad, textura, melanosis, entre otros).
En consecuencia, CKM consciente de que los camarones están expuestos a diario a la interacción con agentes patógenos, así como a un constante estrés fisiológico e inmunológico, presenta a través de su Línea CKM-Aqua, una nueva propuesta mediante un programa destinado a cubrir los puntos críticos que exige la industria camaronera.
“La Línea CKM-Aqua ha desarrollado productos a base de moléculas alternativas como: fitobióticos, ácidos orgánicos, biopolímeros, entre otros, destinados a fortalecer y proteger la integridad intestinal, barrera antibacteriana y regenerar la pared celular de los órganos del camarón.”
Entre las primeras moléculas que trabaja CKM en el sector acuícola se encuentran los fitobióticos, moléculas clasificadas y reconocidas como seguras por la Administración de Alimentos y Fármacos de los Estados Unidos (FDA, por sus siglas en inglés).
Programa AQUA-CKM
Productos Innovadores
El Programa Aqua-CKM está conformado por dos productos fitobióticos (Figura 1), ambos respaldados por un servicio técnico especializado:
✓ Orevitol® AS 20, a base de aceite esencial de orégano, que contiene entre sus sustancias activas al carvacrol y timol.
✓ Liverin-L®, a base de extracto de cardo mariano, cuyo componente es silimarina (combinación de flavolignanos como: silibilina, silicristina y silidianina).

Protocolo de evaluación
Para la Línea CKM-Aqua es clave llevar a cabo protocolos de evaluación que permitan a sus clientes alcanzar el máximo potencial en el uso de los productos naturales alternativos (fitobióticos). Por tal motivo, estos entran en un exhaustivo esquema de evaluaciones que comprende las siguientes fases:
Primera evaluación: se realizan pruebas en laboratorio de diagnóstico, donde se mide la efectividad del producto contra cepas patógenas obtenidas del medio. Para ello, se toman muestras de camarones infectados con el fin de obtener las cepas patógenas y, así, poder evaluar la eficiencia y respuesta inhibitoria del producto.
Segunda evaluación: se efectúan pruebas en ciclos completos de crianza en granjas experimentales, donde se aplican los productos en programas establecidos bajo condiciones normales de trabajo de campo. Este estudio evalúa la eficacia del Programa Aqua-CKM respecto a la mejora de los parámetros productivos.
“De forma simultánea a las evaluaciones experimentales, y gracias a la colaboración de clientes y aliados estratégicos, los productos se ponen a prueba para solucionar problemas de campo en tiempo real (problemas sanitarios, tóxicos, entre otros).”
Además, como política, el servicio técnico de la Línea CKM-Aqua acompaña al acuicultor en todo su proceso productivo para que juntos, al evaluar y analizar las condiciones sanitarias presentes en cada granja y de cada unidad de negocio, se pueda llegar al diagnóstico y proporcionar la mejor solución para abordar el problema.
A continuación, CKM Aqua presenta una serie de estudios realizados en las diferentes etapas productivas, orientados a demostrar los beneficios de los productos fitobióticos Orevitol® AS 20 y Liverin-L® del Programa Aqua-CKM en las distintas etapas de crecimiento del camarón L. vannamei, tanto en ensayos en laboratorio como de campo, como se describe en la Tabla 1.

Resultados
Evaluación: Laboratorio de Análisis
Los productos del Programa Aqua-CKM son continuamente evaluados en laboratorio, para comprobar su efectividad contra los microorganismos y enfermedades emergentes de campo.
En la Figura 2 se aprecia la evaluación microbiológica del producto Orevitol® AS 20 (aceite esencial de orégano), donde se puede observar la difusión en disco mostrando los halos de inhibición
de crecimiento del Vibrio harveyi frente a discos impregnados con Orevitol® AS 20.
Asimismo, se realizó la evaluación de Orevitol® AS 20 vs. Pseudomonas sp y vs. Vibrio parahemolyticus, con resultados de inhibición del crecimiento.
Como parte de los análisis en laboratorio, se condujo la evaluación clínico patológica de hepatopáncreas después del uso del Liverin-L® (extracto de cardo mariano).
En la Figura 3 se muestra los túbulos hepatopancreáticos con una necrosis leve y la estructura de la
pared difusa (Figura 3A), mientras que, el uso de Liverin-L® favorece la integridad del hepatopáncreas, lo que se demuestra a través de las paredes lisas y estructura conservada de este órgano (Figura 3B).

Evaluación: Laboratorio de Larvas
La evaluación de las larvas de camarón L. vannamei se realizó entre los meses de noviembre y diciembre de 2021. Cada evaluación se realizó por triplicado con sus respectivos testigos. Los resultados demuestran la eficiencia del Programa Aqua-CKM, al obtener mayor supervivencia aun trabajando a altas densidades (Tabla 2).

Evaluación: Raceways
Se realizó una primera evaluación de raceways en febrero de 2022. Los hallazgos arrojaron una mayor supervivencia de 7.42% con el Programa Aqua-CKM vs. el testigo (Tabla 3). Posteriormente, en las siguientes evaluaciones se obtuvo entre un 10% y 15% adicional en supervivencia respecto a los testigos en una segunda evaluación (agosto, 2022).

En ambas evaluaciones del Programa Aqua-CKM en raceways, se logró obtener nuevos y mejores estándares, así como mayor supervivencia respecto a sus testigos, además de una reducción significativa de microorganismos patógenos según análisis de laboratorio.
Evaluación: Precría y Engorda
La evaluación de precría se realizó en febrero de 2022. Los resultados demostraron una tendencia del Programa Aqua-CKM en lograr mayor supervivencia (Tabla 4). La evaluación de engorda se llevó a cabo en septiembre de 2022, observándose que los estanques con el Programa Aqua-CKM, empezaron con un incremento de peso semanal inferior al testigo, logrando al final de campaña superarlo en peso.

La edad de inicio fue de 36 días y la ubicación de las evaluaciones fue Tumbes, Perú (Tabla 5).

Resultados de Campo
A través de las evaluaciones en la granja experimental se demostró que el uso continuo del Programa Aqua-CKM en diferentes épocas del año, permite lograr mejores parámetros productivos, alcanzando nuevos estándares, como se muestra en todas las evaluaciones (Tabla 6).

Conclusiones
La utilización continua del Programa Aqua-CKM en la crianza del camarón L. vannamei durante toda su etapa productiva, afecta de manera positiva su productividad. Asimismo, Orevitol® AS 20 y Liverin-L® (productos fitobióticos) demostraron que:
✓ Trabajan como una barrera anti-bacteriana natural.
✓ Favorecen la integridad intestinal.
✓ Optimizan la ganancia de peso.
✓ Estimulan el crecimiento del organismo.
✓ Mejoran la conversión alimenticia.
✓ Regeneran, mantienen y limpian sus órganos.
“Una vez más, se confirma la efectividad generada por el uso continuo del Programa Aqua-CKM a través del tiempo, mejorando y mantenido los parámetros productivos exigidos por el mercado acuícola mundial”.
Este artículo es patrocinado por CKM
Esta es una versión resumida desarrollada por el equipo editorial de Panorama Acuícola Magazine del artículo “CKM, EMPRESA PERUANA, QUE CONTRIBUYE CON UN PROGRAMA INNOVADOR, CON PRODUCTOS ALTERNATIVOS Y NATURALES, QUE POTENCIAN LA SOSTENIBILIDAD Y RENTABILIDAD DEL SECTOR” escrito por ING. JAVIER SOTO, ING. PESQUERO LUIS HURTADO Y LIC. ANDREA MUÑOZ-CKM.












